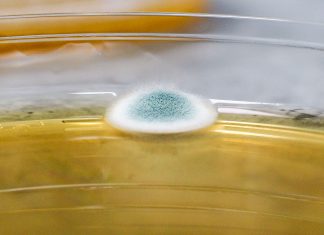
TESTY MIKROBIOLOGICKÉ STABILITY VÍNA

TESTY MIKROBIOLOGICKÉ STABILITY VÍNA
Společnost BS vinařské potřeby před nedávnem otevřela zcela novou část své BS laboratoře ve Velkých Bílovicích. Ta se zabývá testováním mikrobiologické stability vína. Tento...
Večeře v Oblacích je v Praze nejkrásnější! Hned tři víkendy v...
Romantika nejen při západu slunce, parádní gastronomie a trocha adrenalinu. Takové jsou tři nezbytné pilíře stále oblíbenější atrakce, pro kterou se již vžil název...
Gruzie láká na víno, přírodu, moře, historii… Letos však bez ruských...
Hledáte destinaci, kde najdete hory, moře, řeky, historická města, autentické vesničky, skvělé víno, božskou gastronomii a na plážích není nabito? Pak je Gruzie skvělá...
KDYŽ SE SÍLY SPOJÍ BOURGOGNE MILLÉSIMES 2019
Různé styly, různé oblasti, ale velmi zajímavá kvalita. Společnosti Advivum a Merlot d’Or nabídly návštěvníkům krásný zážitek z vín ročníků 2012–2017.
Vína z apelací Chalblis, Gevrey Chambertin,...
ŠAMPIONEM ČERVNOVÉHO HODNOCENÍ VÍN SOUTĚŽE „SUCHÁ VÍNA ONLINE“ SE STAL PINOT...
Ve Valticích letos již podruhé uskutečnilo hodnocení vín do soutěže „Suchá vína online“. Přítomní členové Unie enologů degustovali 10 vzorků, z nichž nejlépe uspěl Pinot...
Milujeme prosecco! Už po šesté!
Oblíbený festival zasvěcený italským bublinkám, gastronomii, módě a designu se vrací na začátku léta. Přijďte si připít v sobotu 22. června do Riegrových sadů. Na...
Nejlepším barmanem České republiky je Tomáš Nyári
Tomáš Nyári je novým nejlepším barmanem České republiky. Zvítězil nad takřka padesátkou dalších soutěžících z 27 špičkových barů z celé České republiky. Po půlročním náročném...
PRAŽSKÉ VINICE 2019 ...
Pražské vinice a vinařství otevírají již potřetí své brány v rámci ještě mladého, ale už populárního projektu Hlavního města Prahy. Komentované prohlídky, perličky z historie...
Největší pražská ryzlinková party již zítra! Nenechte si ujít RIESLING ROCKS...
Vína z bílé královké odrůy pod širým nebem, Riesling Open Air již zítra na pražském Senovážném náměstí. Skleničky do ruky a jedme! Skvělé víno,...
Garden Food Festival
Snídaně z moučných červů, kohoutí perkelt, valašský krém nebo černá kozí zmrzlina. Garden Food festival nabídne klasiku i exotické delikatesy
Krevetové knedlíky, vegetariánské koule ze směsi...
Medailová vína a nadívané prasátko
Deštivý týden je snad už konečně za námi a plánujete kam vyrazit o víkendu? Medailová vína a nadívané prasátko na vás čekají v rámci...
Gruzínské dny v Praze, která opět „Pije víno…“
Šestý ročník největšího vinařského festivalu v metropoli zaměřeného na autentická vína ze střední Evropy Praha pije víno odstartuje už tento pátek tradičně v historických...
Syn „Papeže Crozes – Hermitage“ Maxime Graillot
Maxime Graillot je starším synem pana Alaina Graillota, který proslavil apelaci Crozes-Hermitage po celém světě. Právem se mu přezdívá „papež Crozes-Hermitage“. Díky němu je...
FILMOVÝ ZLÍN PŘEJE CESTOVÁNÍ, ČESKÝM FILMŮM I CHUTÍM
Bez cest a objevů cizích kultur by byl svět šedivý, což platí nejen pro gastronomické a vinařské zážitky. Právě v duchu objevování a poznávání se...
Největší rumový festival roztančí Žluté lázně
Šestý ročník akce Rumfest by Barlife, zábavně vzdělávací oslavy pravého třtinového rumu určené především široké veřejnosti, se uskuteční v sobotu 18. května 2019. Stejně jako...
Skvělá slovinská domácí kuchyně Farma Pri Kovačniku
Květnoví zmrzlí muži ještě trochu úřadují, ale už nastává ideální čas, na plánování dovolených, nebo prodloužených víkendů. Během našeho redakčního cestování za vínem a...
Biodynamik Goisot navštívil Prahu
Prahu navštívil francouzský vinař Guilhem Goisot, který představil své speciality z oblasti Severního Burgundska. Guilhem v současnosti nejdůležitějším člověkem rodinného vinařství Goisot působícího po generace ve...
Hostit Concours Mondial de Bruxelles bude v roce 2020 Brno
Česká republika bude příští rok hostit nejprestižnější vinařskou soutěž světa. Město Brno bylo vybráno k hostování Concourse Mondial de Bruxelles 2020. Starosta města Aigle,...
Otevřené sezení venku i nové menu v Babiččině zahradě
Pestrou kolekci svěžích novinek připravil pro své hosty šéfkuchař průhonické restaurace Babiččina zahrada Michal Šorf. Novému menu vládnou sezónní speciality z lahodného chřestu a...
Soutěž Cuvée Ostrava rozdala medaile
Sedmnáctý ročník jedinečné mezinárodní soutěže kupáží, asambláží a známkových vín uspořádal uděloval medaile. Hlavní ceny putovaly vedle našich vinařství na Slovensko, do Itálie, Maďarska,...